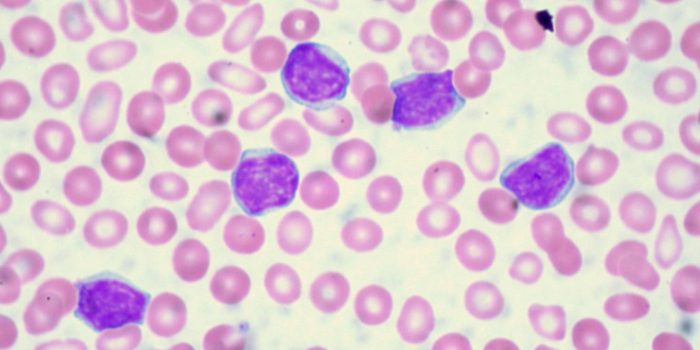

在类型的癌症中,白血病是致命的一种。科学家们仍然没有完全理解它,并且它的治疗也可能很复杂。它完全取决于患者以及其他变量的白血病。但是,有一些方法和资源可增强治疗的有效性。
最近的研究促进了白血病的治疗方法。根据《耶路撒冷邮报》发表的一份新报告,由西班牙巴塞罗那的一支西班牙和以色列科学家团队进行的研究将高度增殖的白血病细胞通过改变其信使RNA的化学修饰来恢复了正常无害细胞。

该小组对《耶路撒冷邮报》说:“我们知道,人类肿瘤必须躲避药物有效性的一种策略是改变其外观,成为另一个类似的癌症,但对所使用的药物不敏感。”“例如,淋巴样谱系的白血病切换到髓样菌株以逃避治疗。”
科学家研究了一种体外模型,通过该模型,白血病细胞可以转变为无害的免疫细胞,称为巨噬细胞。这些分子中两个相邻化学键产生的角度的变化导致蛋白质定义白血病变得不稳定,从而使巨噬细胞能够出现。

Manel博士说:“针对该靶标的临床前药物已经在恶性血液疾病的实验模型中已经开发出来,因此我们提供了另一个原因,为什么这些新型药物可以在癌症疗法中有用,尤其是在白血病和淋巴瘤的情况下。”埃斯泰勒(Esteller)是巴塞罗那大学何塞普·卡雷拉斯白血病研究所的负责人。
它尚待对患者进行测试。但是,这似乎很有希望。可以预料,将白血病细胞转化为非癌细胞将是击败癌症的新方法。
该研究的结果已发表在白血病杂志上。